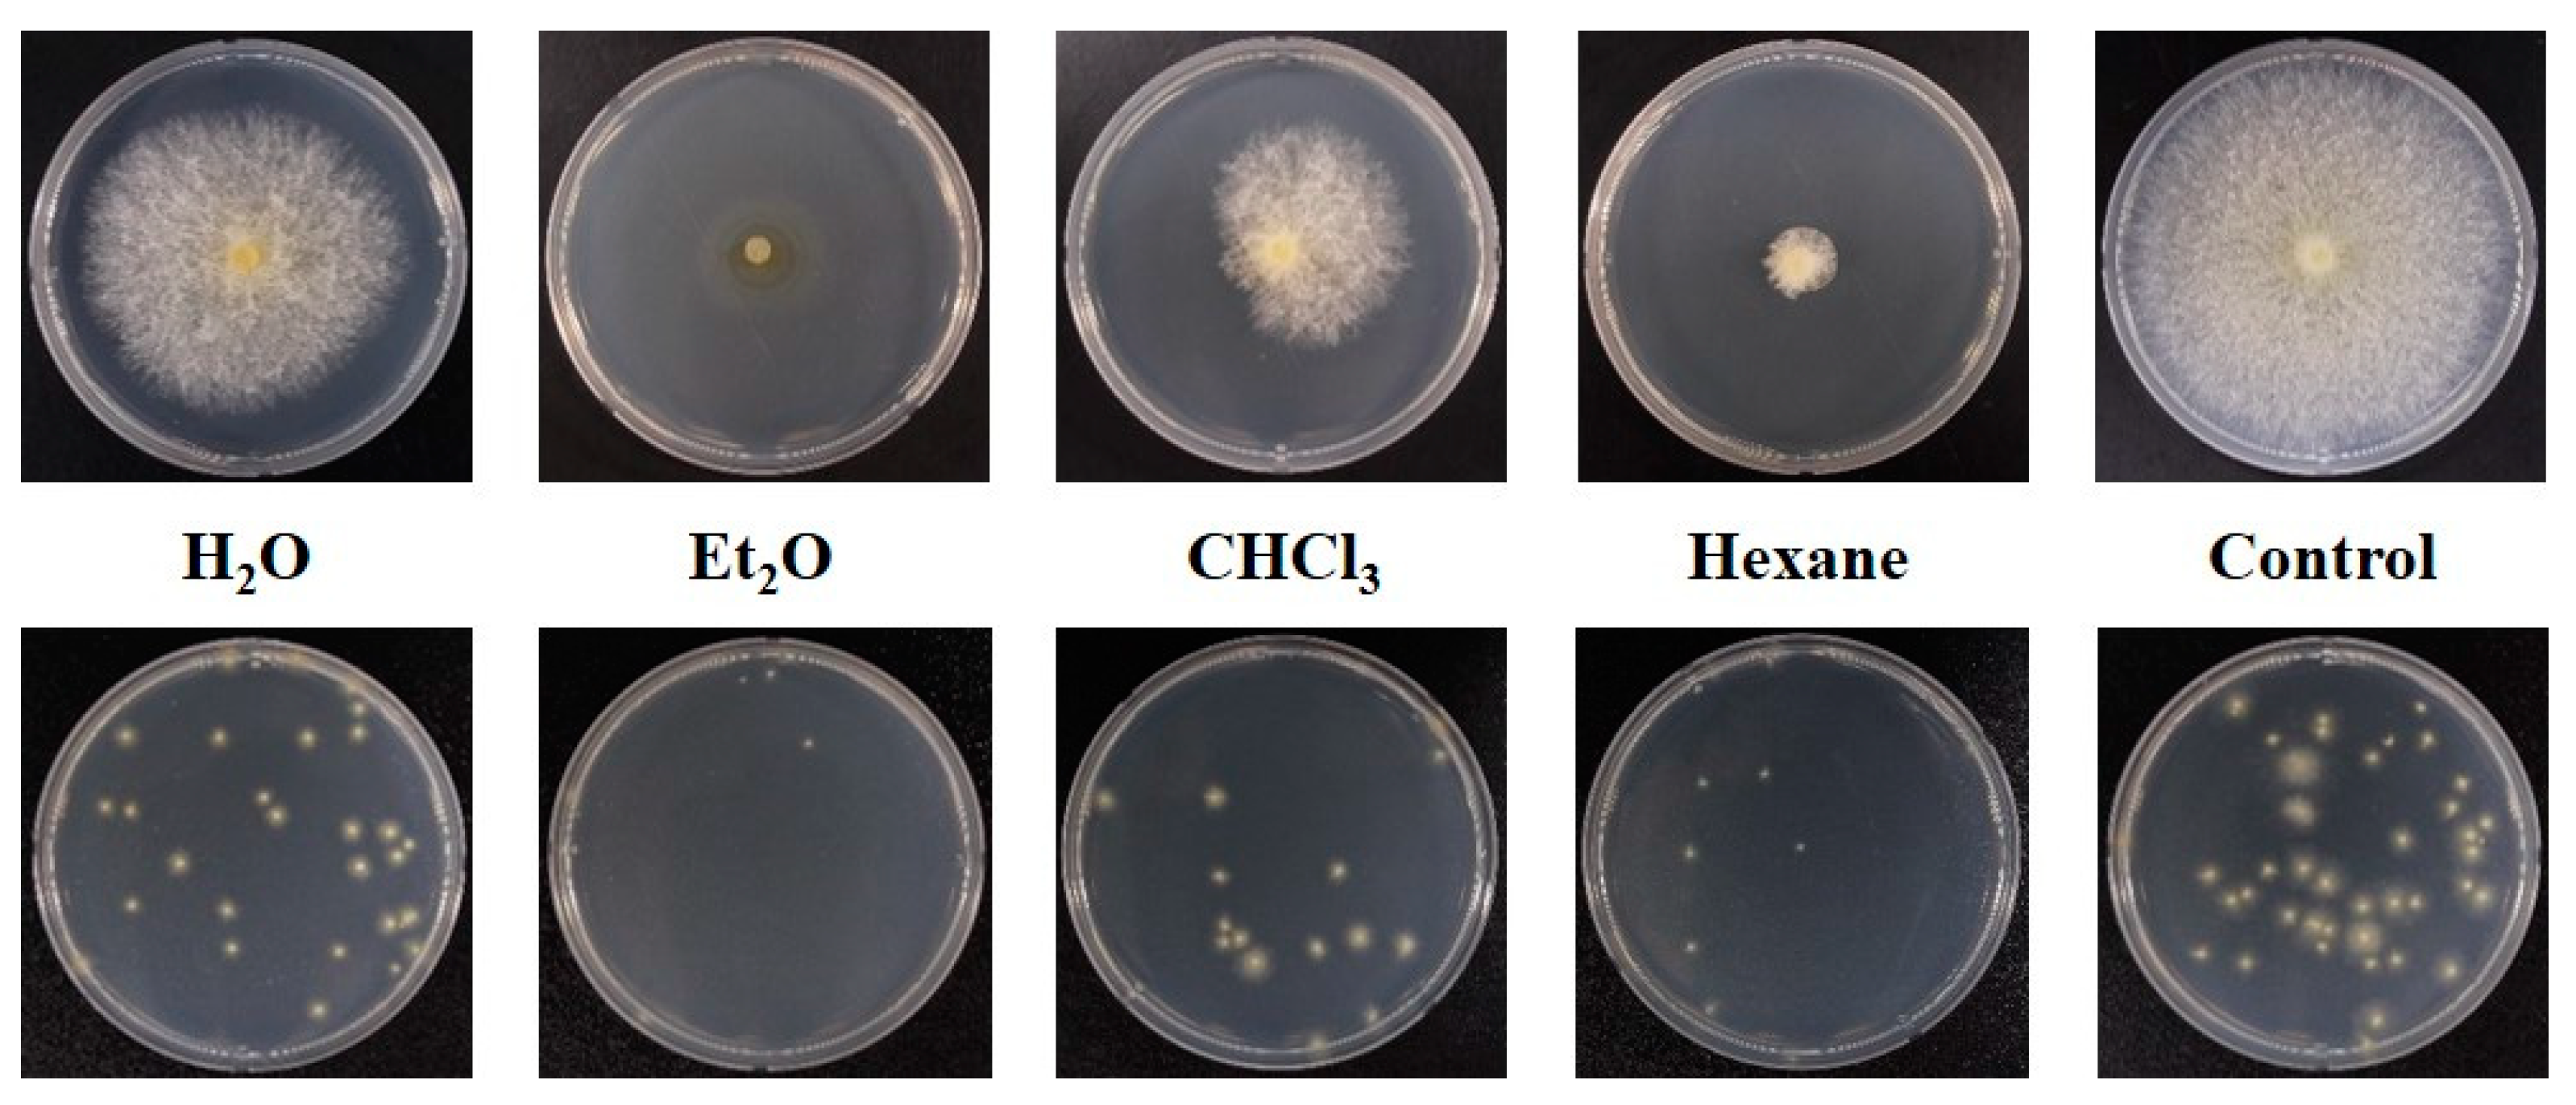
Forests 15 00332 g007

Antifungal Activity of Culture Filtrate from Endophytic Fungus Nectria balsamea E282 and Its Fractions against Dryadomyces quercus-mongolicae
Abstract
1. Introduction
2. Materials and Methods
2.1. Preparation of Culture Filtrate and Experimental Design
2.2. Assessment of Antifungal Activity of Culture Filtrates against D. quercus-mongolicae
2.3. Extraction and Isolation of Fractions from Nectria balsamea E282
2.4. Assessment of Antifungal Activity of Fractions
2.5. Statistical Analysis
3. Results
3.1. Mycelial Growth of D. quercus-mongolicae on Culture Filtrates
3.2. Inhibition Activities of Culture Filtrates against D. quercus-mongolicae
3.3. Inhibition Activities of Fractions from Nectria balsamea E282 against D. quercus-mongolicae
4. Discussion
5. Conclusions
Author Contributions
Funding
Data Availability Statement
Acknowledgments
Conflicts of Interest
References
- Aly, A.H.; Debbab, A.; Proksch, P. Fungal endophytes: Unique plant inhabitants with great promises. Appl. Microbiol. Biotechnol. 2011, 90, 1829–1845. [Google Scholar] [CrossRef] [PubMed]
- Paul, N.C.; Yu, S.H. Endophytic Fungi from Medicinal Plants in Korea; Lap Lambert Academic Publishing: Saarbrücken, Germany, 2011; ISBN 978-3-8473-0777-8. [Google Scholar]
- Rashmi, M.; Kushveer, J.S.; Sarma, V.V. A worldwide list of endophytic fungi with notes on ecology and diversity. Mycosphere 2019, 10, 798–1079. [Google Scholar] [CrossRef]
- Guo, B.; Wang, Y.; Sun, X.; Tang, K. Bioactive natural products from endophytes: A review. Appl. Biochem. Microbiol. 2008, 44, 136–142. [Google Scholar] [CrossRef]
- Rana, K.L.; Kour, D.; Sheikh, I.; Dhiman, A.; Yadav, N.; Yadav, A.N.; Rastegari, A.A.; Singh, K.; Saxena, A.K. Endophytic fungi: Biodiversity, ecological significance, and potential industrial applications. In Recent Advancement in White Biotechnology through Fungi; Yadav, A.N., Mishra, S., Singh, S., Gupta, A., Eds.; Fungal Biology; Springer International Publishing: Cham, Switzerland, 2019; pp. 1–62. ISBN 978-3-030-10479-5. [Google Scholar]
- Plácido, J.; Capareda, S. Ligninolytic enzymes: A biotechnological alternative for bioethanol production. Bioresour. Bioprocess. 2015, 2, 23. [Google Scholar] [CrossRef]
- Hartley, S.E.; Gange, A.C. Impacts of plant symbiotic fungi on insect herbivores: Mutualism in a multitrophic context. Annu. Rev. Entomol. 2009, 54, 323–342. [Google Scholar] [CrossRef] [PubMed]
- Sun, X.; Guo, L.-D. Endophytic fungal diversity: Review of traditional and molecular techniques. Mycology 2012, 3, 65–76. [Google Scholar] [CrossRef]
- Arora, J.; Ramawat, K.G. An introduction to endophytes. In Endophytes: Biology and Biotechnology; Maheshwari, D.K., Ed.; Sustainable Development and Biodiversity; Springer International Publishing: Cham, Switzerland, 2017; Volume 1, pp. 1–23. ISBN 978-3-319-66541-2. [Google Scholar]
- Erbert, C.; Lopes, A.A.; Yokoya, N.S.; Furtado, N.A.J.C.; Conti, R.; Pupo, M.T.; Lopes, J.L.C.; Debonsi, H.M. Antibacterial compound from the endophytic fungus Phomopsis longicolla isolated from the tropical red seaweed Bostrychia radicans. Bot. Mar. 2012, 55, 435–440. [Google Scholar] [CrossRef]
- Comby, M.; Gacoin, M.; Robineau, M.; Rabenoelina, F.; Ptas, S.; Dupont, J.; Profizi, C.; Baillieul, F. Screening of wheat endophytes as biological control agents against Fusarium head blight using two different in vitro tests. Microbiol. Res. 2017, 202, 11–20. [Google Scholar] [CrossRef]
- McMullin, D.R.; Green, B.D.; Prince, N.C.; Tanney, J.B.; Miller, J.D. Natural products of Picea endophytes from the Acadian forest. J. Nat. Prod. 2017, 80, 1475–1483. [Google Scholar] [CrossRef]
- Santiago, C.; Fitchett, C.; Munro, M.H.G.; Jalil, J.; Santhanam, J. Cytotoxic and antifungal activities of 5-hydroxyramulosin, a compound produced by an endophytic fungus isolated from Cinnamomum mollisimum. Evid. Based Complement. Altern. Med. 2012, 2012, 689310. [Google Scholar] [CrossRef]
- Bhalkar, B.N.; Bedekar, P.A.; Patil, S.M.; Patil, S.A.; Govindwar, S.P. Production of camptothecine using whey by an endophytic fungus: Standardization using response surface methodology. RSC Adv. 2015, 5, 62828–62835. [Google Scholar] [CrossRef]
- Bhalkar, B.N.; Patil, S.M.; Govindwar, S.P. Camptothecine production by mixed fermentation of two endophytic fungi from Nothapodytes nimmoniana. Fungal Biol. 2016, 120, 873–883. [Google Scholar] [CrossRef]
- Nishad, J.H.; Singh, A.; Gautam, V.S.; Kumar, D.; Kumar, J.; Kharwar, R.N. Endophytic fungi: A cryptic fountainhead for biodiversity, functional metabolites, host stress tolerance, and myco-mediated nanoparticles (Nps) synthesis. In Endophytes and Secondary Metabolites; Jha, S., Ed.; Reference Series in Phytochemistry; Springer International Publishing: Cham, Switzerland, 2018; pp. 1–29. ISBN 978-3-319-76900-4. [Google Scholar]
- Kim, K.-H.; Choi, Y.-J.; Seo, S.-T.; Shin, H.-D. Raffaelea quercus-mongolicae sp. nov. associated with Platypus koryoensis on oak in Korea. Mycotaxon 2009, 110, 189–197. [Google Scholar] [CrossRef]
- Lee, D.-H.; Son, S.-Y.; Seo, S.-T.; Lee, J.K. Investigation of the mating-type distribution of Raffaelea quercus-mongolicae in South Korea. For. Pathol. 2020, 50, e12590. [Google Scholar] [CrossRef]
- De Beer, Z.W.; Procter, M.; Wingfield, M.J.; Marincowitz, S.; Duong, T.A. Generic boundaries in the Ophiostomatales reconsidered and revised. Stud. Mycol. 2022, 101, 57–120. [Google Scholar] [CrossRef] [PubMed]
- Lee, S.H.; Lee, S.K.; Kim, J.Y.; Lee, C.K.; Kim, K.H.; Yi, Y.S. Antifungal property of microorganisms against Korea oak wilt pathogen, Raffaelea quercus-mongolicae. Korean J. Microbiol. Biotechnol. 2012, 40, 66–69. [Google Scholar] [CrossRef]
- Hong, A.R.; Yun, J.H.; Yi, S.H.; Lee, J.H.; Seo, S.T.; Lee, J.K. Screening of antifungal microorganisms with strong biological activity against oak wilt fungus, Raffaelea quercus-mongolicae. J. For. Environ. Sci. 2018, 34, 395–404. [Google Scholar] [CrossRef]
- Nguyen, M.H.; Yong, J.H.; Sung, H.J.; Lee, J.K. Screening of endophytic fungal isolates against Raffaelea quercus-mongolicae causing oak wilt disease in Korea. Mycobiology 2020, 48, 484–494. [Google Scholar] [CrossRef]
- Yong, J.H. Diversity Analysis of Endophytic Fungi Isolated from Pine and Oak Trees in Korea. Master’s Thesis, Kangwon National University, Chuncheon, Republic of Korea, 2019. [Google Scholar]
- Booth, C. Studies of pyrenomycetes: IV Nectria (Part 1). Mycol. Pap. 1959, 73, 1–117. [Google Scholar]
- Wenner, N.G.; Merrill, W.; Moody, J.T. Thyronectria balsamea on Abies fraseri in Pennsylvania and North Carolina. Plant Dis. 1997, 81, 830. [Google Scholar] [CrossRef]
- Guu, J.-R.; Ju, Y.-M.; Hsieh, H.-J. Nectriaceous fungi collected from forests in Taiwan. Bot. Stud. 2007, 48, 187–203. [Google Scholar]
- Rubini, M.R.; Silva-Ribeiro, R.T.; Pomella, A.W.V.; Maki, C.S.; Araújo, W.L.; dos Santos, D.R.; Azevedo, J.L. Diversity of endophytic fungal community of cacao (Theobroma cacao L.) and biological control of Crinipellis perniciosa, causal agent of witches’ broom disease. Int. J. Biol. Sci. 2005, 1, 24–33. [Google Scholar] [CrossRef] [PubMed]
- Lin, X.; Huang, Y.J.; Zheng, Z.H.; Su, W.J.; Qian, X.M.; Shen, Y.M. Endophytes from the pharmaceutical plant, Annona squamosa: Isolation, bioactivity, identification and diversity of its polyketide synthase gene. Fungal Divers. 2010, 41, 41–51. [Google Scholar] [CrossRef]
- Wu, H.; Yang, H.-Y.; You, X.-L.; Li, Y.-H. Diversity of endophytic fungi from roots of Panax ginseng and their saponin yield capacities. SpringerPlus 2013, 2, 107. [Google Scholar] [CrossRef]
- Cui, H.; Liu, Y.; Nie, Y.; Liu, Z.; Chen, S.; Zhang, Z.; Lu, Y.; He, L.; Huang, X.; She, Z. Polyketides from the mangrove-derived endophytic fungus Nectria sp. HN001 and their α-glucosidase inhibitory activity. Mar. Drugs 2016, 14, 86. [Google Scholar] [CrossRef]
- Cota, B.B.; Tunes, L.G.; Maia, D.N.B.; Ramos, J.P.; de Oliveira, D.M.; Kohlhoff, M.; de Almeida Alves, T.M.; Souza-Fagundes, E.M.; Campos, F.F.; Zani, C.L.; et al. Leishmanicidal compounds of Nectria pseudotrichia, an endophytic fungus isolated from the plant Caesalpinia echinata (Brazilwood). Memórias Inst. Oswaldo Cruz 2018, 113, 102–110. [Google Scholar] [CrossRef]
- Ariefta, N.R.; Kristiana, P.; Nurjanto, H.H.; Momma, H.; Kwon, E.; Ashitani, T.; Tawaraya, K.; Murayama, T.; Koseki, T.; Furuno, H.; et al. Nectrianolins A, B, and C, new metabolites produced by endophytic fungus Nectria pseudotrichia 120-1NP. Tetrahedron Lett. 2017, 58, 4082–4086. [Google Scholar] [CrossRef]
- Shiono, Y.; Koyama, H.; Murayama, T.; Koseki, T. New sesquiterpenes from the endophyte Microdiplodia sp. TT-12 and their antimicrobial activity. Phytochem. Lett. 2015, 14, 143–147. [Google Scholar] [CrossRef]
- Koch, K.A.; Quiram, G.L.; Venette, R.C. A review of oak wilt management: A summary of treatment options and their efficacy. Urban For. Urban Green. 2010, 9, 1–8. [Google Scholar] [CrossRef]
- Lee, J.H.; Hong, A.R.; Yun, J.H.; Seo, S.T.; Lee, J.K. Prevention of oak wilt by tree injection of culture suspension of an antifungal microorganism, Streptomyces blastmyceticus against oak wilt fungus, Raffaelea quercus-mongolicae. J. For. Environ. Sci. 2018, 34, 376–381. [Google Scholar] [CrossRef]

Disclaimer/Publisher’s Note: The statements, opinions and data contained in all publications are solely those of the individual author(s) and contributor(s) and not of MDPI and/or the editor(s). MDPI and/or the editor(s) disclaim responsibility for any injury to people or property resulting from any ideas, methods, instructions or products referred to in the content. |
© 2024 by the authors. Licensee MDPI, Basel, Switzerland. This article is an open access article distributed under the terms and conditions of the Creative Commons Attribution (CC BY) license (https://creativecommons.org/licenses/by/4.0/).
Share and Cite
Nguyen, M.H.; Park, I.-K.; Lee, J.K.; Lee, D.-H.; Shin, K. Antifungal Activity of Culture Filtrate from Endophytic Fungus Nectria balsamea E282 and Its Fractions against Dryadomyces quercus-mongolicae. Forests 2024, 15, 332. https://doi.org/10.3390/f15020332
Nguyen MH, Park I-K, Lee JK, Lee D-H, Shin K. Antifungal Activity of Culture Filtrate from Endophytic Fungus Nectria balsamea E282 and Its Fractions against Dryadomyces quercus-mongolicae. Forests. 2024; 15(2):332. https://doi.org/10.3390/f15020332
Chicago/Turabian StyleNguyen, Manh Ha, Il-Kwon Park, Jong Kyu Lee, Dong-Hyeon Lee, and Keumchul Shin. 2024. "Antifungal Activity of Culture Filtrate from Endophytic Fungus Nectria balsamea E282 and Its Fractions against Dryadomyces quercus-mongolicae" Forests 15, no. 2: 332. https://doi.org/10.3390/f15020332
APA StyleNguyen, M. H., Park, I.-K., Lee, J. K., Lee, D.-H., & Shin, K. (2024). Antifungal Activity of Culture Filtrate from Endophytic Fungus Nectria balsamea E282 and Its Fractions against Dryadomyces quercus-mongolicae. Forests, 15(2), 332. https://doi.org/10.3390/f15020332

